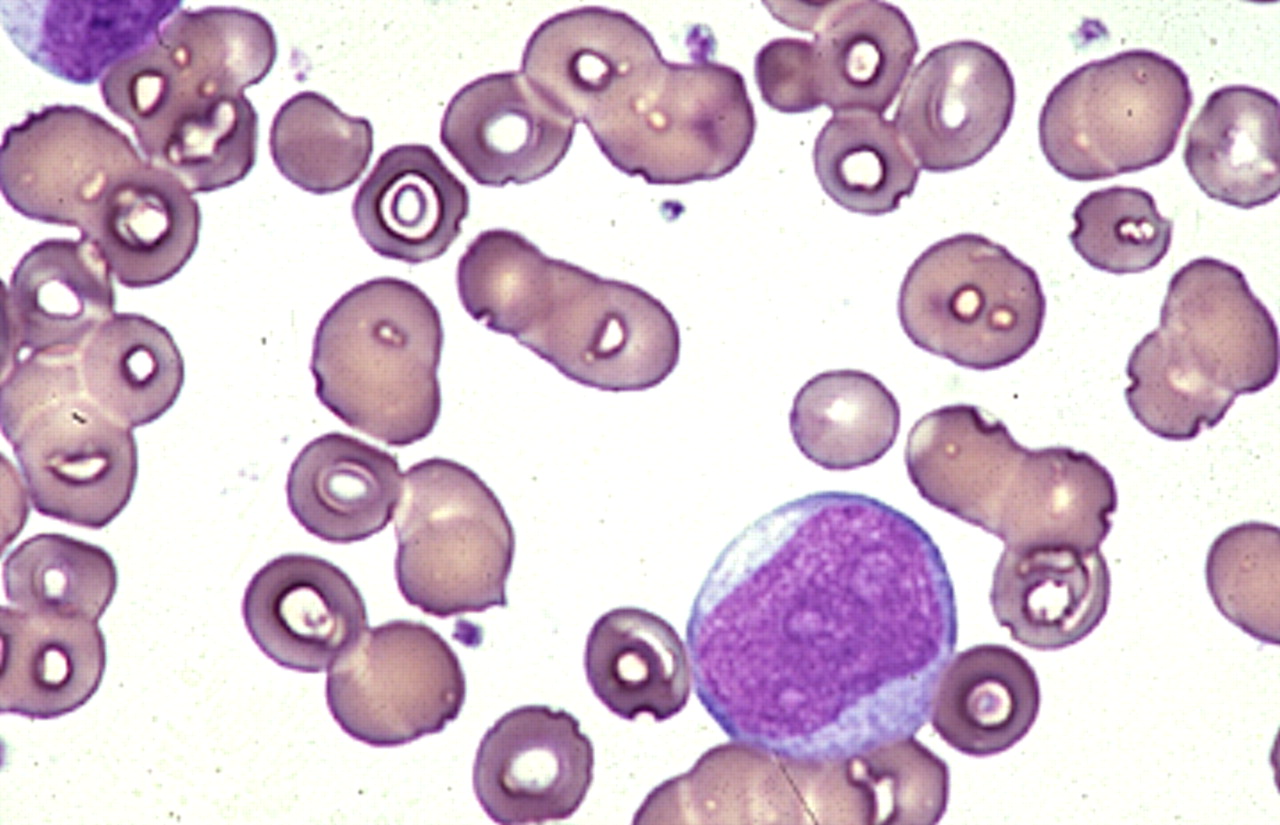

|
Java Games: Flashcards, matching, concentration, and word search. |
 |
 |
Therapy related AML
Take this quiz to reinforce learning about therapy related AML
|
| A | B |
| What per centage of all new AML are related to prior rad rx or chemorx therapy ? | 10-20% |
| What is latency period from start of an alkylatin agent to the development of t-AML? | 5-7 years |
| What class of chenmotherapy agents has a short latency of 1-3 years and they uusually present with acute leukemia instead of MDS ? | Topoisomerase II inhibitors |
| If the blast count is low what chromosome changes suggest the leukemia os therpay related aml ? | t(8,21); inv(16) |
| The management of t-AML should be guided by karyotype and ? | performance status |
| True or false t-APL is managed the same as denovo APL? | True |
What type of cell ?, | Blast aml |
What do you see,  | auer rods in aml blast |
| an bfsnn | tdtjm |
| axn ftgukj | gtkjdjm |
|
 |
|
|
|
Professor |
Medical University of South Carolina |
| Charleston, SC |
|
|
|
|
|
| |